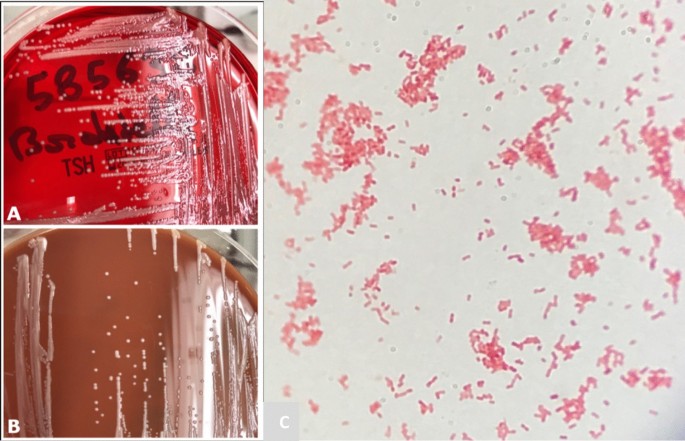
figure2

- Case report
- Open access
- Published:
Erysipelas of the right arm due to Bordetella trematum: a case report
Journal of Medical Case Reports volume 15, Article number: 365 (2021)
Abstract
Background
Bordetella trematum is unknown to most clinicians and microbiologists. However, this Gram-negative opportunistic bacterium can be responsible for ulcer superinfection but also bacteremia and sometimes death by septic shock.
Case report
We report the case of erysipelas due to B. trematum with bacteremia in an immunocompromised 88-year-old Caucasian patient.
Conclusion
In immunocompromised patients, unusual microbial agents such as B. trematum can be responsible for cutaneous and systemic infections, requiring specific antibiotic therapy. Therefore, clinicians should be aware of the need for specific bacterial identification such as matrix-assisted laser desorption ionization time-of-flight mass spectrometry and 16S ribosomal RNA sequencing in the context of atypical evolution of erysipelas in such patients.
Introduction
The genus Bordetella belongs to the Alcaligenaceae family and includes dozens of species [1, 2] mostly responsible for bronchopulmonary infections in mammals. The agent of whooping cough, Bordetella pertussis, is the most famous of Bordetella species. Bordetella trematum was identified in 1996 from chronic media otitis and chronic ulcer [3]. This germ is difficult to isolate, and its pathogenicity remains debated in humans. An increasing number of infections due to B. trematum are described in the literature as a potential emerging pathogen. In this context, we report the case of erysipelas due to B. trematum associated with bacteremia.
Case
An 88-year-old Caucasian male patient had a history of chronic kidney failure, stress angina with quadruple coronary bypass surgeries, removal of multiple skin carcinomas, and chronic lymphocytic leukemia treated for a year by chloraminophene in 2012. This former carpenter, who normally lived alone, presented himself to emergency unit for repeated falls and erythematous edema of the right arm since 3 days suggesting erysipelas (Fig. 1). On admission, his temperature was 39.7 °C, his pulse was at 107 beats per minute, and blood pressure was 131/54 mmHg. He presented erysipelas of the right arm with edema and without any adenopathy. There was no other clinical sign at admission. The blood test found leukocytes at 156 × 109/L consisting of 12.8 × 109/L neutrophils and 140 × 109/L lymphocytes, serum biochemical analysis with creatinine level at 160 µmol/L, hyperkalemia at 5.3 mmol/L, and elevated C-reactive protein (CRP) at 271 mg/L. One set of blood culture was collected from a peripheral access prior to administration of amoxicillin, and the patient was transferred to the geriatric unit. Aerobic blood culture grew with small, gray, shiny, rounded colonies in polyvitex and blood agar plate (Fig. 2a, b), which were Gram-negative coccobacilli (Fig. 2c) after 18 h at 35° CO2 on conventional medium. B. trematum was identified using matrix-assisted laser desorption ionization time-of-flight mass spectrometry (MALDI-TOF MS) and confirmed by 16S ribosomal RNA sequencing (Additional file 1). Another blood culture was performed 2 days after the first one and while taking antibiotic therapy and was negative. No additional tests were carried out. Diagnosis of thrombosis was eliminated by venous ultrasonography and Doppler of his right arm.
After a multidisciplinary meeting involving geriatricians, infectious diseases specialists, and microbiologists, antibiotic therapy was changed to ceftazidime 1 g per day for 10 days after a charging dose of 2 g, slow intravenous, according to susceptibility testing (Table 2) and renal function at that time. The clinicobiological evolution was rapidly favorable. The patient was discharged from hospital and referred to hematologists on the basis of white blood cell count, and finally, the chemotherapy by chloraminophene was resumed. He was rehospitalized for depression the next month, at which point his arm was totally healed. At the last follow-up, 6 months after the first symptoms, the patient was in good health and has not had any recurrence of infection.
Discussion
Our case illustrates an atypical case of erysipelas in an immunocompromised patient. Identification of B. trematum required MALDI-TOF and 16S-rtPCR sequencing, and lead to modification of empiric antibiotic treatment for ceftazidime with good evolution.
Bordetella trematum is a small, mobile, capsulated, nonsporulating, and nonfermentative Gram-negative bacillus. The term trema refers to something pierced or penetrated like wounds, and inspired its name [1]. Little is known about its pathophysiology because it is scarce and quite recently identified. It is genetically close to B. avium and frequently mistaken for it [4]. The supposed ecological reservoir of B. trematum is soil [5], and most cases involve skin and soft-tissue infections. Chang et al. have revealed a cytolethal distending toxin (CDT) [6]. This genotoxin has only been described in B. trematum, which may partly explain the ineffectiveness of antibiotic treatment in some patients. It could be interesting to better characterize the role of this genotoxin in the specific virulence of B. trematum, and evaluate the specific effect of antitoxin antibiotic drugs such as macrolides.
The interpretation of a positive blood culture of B. trematum remains difficult and, in the context of sepsis, should prompt a suitable antibiotic therapy. Thanks to new diagnostic tools such as MALDI-TOF and molecular biology, it is now easier to identify [7,8,9,10,11,12], though there are still mistakes in its recognition.
Bordetella trematum infections have been identified in 14 case reports in the literature (12 are summarized in Table 1). Most cases were found in diabetic patients, particularly from ulcers and chronic ear infections [1, 4, 7, 9, 12]. Several authors consider that this germ is not very pathogenic and that its natural evolution does not require specific antibiotherapy [4, 7].
In contrast, as reported with our patient, invasive infection seems to occur mostly in immunocompromised patient [8, 13, 14]. Thereby, B. trematum could be considered as an opportunistic agent. However, some cases are reported in immunocompetent patients such as in a 7-month-old child [11] or in a 54-year-old patient with peritonitis [10].
Once the bacteria have been identified, treatment is not consensual. Indeed, there are no data about the antibiotic susceptibility of B. trematum in European guidelines (European Committee on Antimicrobial Susceptibility Testing, EUCAST 2018). We have reported in Table 2 the different antibiotic susceptibility tests described in the literature. There were interpreted according to minimal inhibitory concentration (MIC) interpretative standards of closely related species (other non-Enterobacteriaceae and Enterobacteriaceae). The choice of ceftazidime in our case was made according to the sensitivity testing. Despite the piperacillin–tazobactam sensitivity in vitro in all precedent case reports, patients died despite piperacillin–tazobactam therapy in two of them [12, 13] and had an unfavorable outcome in another one [11], whereas, in the case of Hernandez-Porto et al., the patient had also renal failure and the treatment was a success. Given these discordant results, the place of piperacillin–tazobactam in the therapeutic strategy for the treatment of B. trematum infections should be reconsidered.
Furthermore, clinicians should remain cautious, especially in immunocompromised patient, when presented with atypical skin infection.
Conclusion
Bordetella trematum can be considered as an opportunistic agent scarcely described but with a pathogenicity not to be neglected because of its wide range of severity: from simple colonization to septic shock. This agent, which is increasingly identified, could be considered as a potential emerging pathogen. Therefore, clinicians should be aware of the need for specific means of bacterial identification such as MALDI-TOF and 16S-rtPCR in the context of complicated evolution of erysipelas or associated unidentified Gram-negative bacteremia in immunocompromised patients.
Availability of data and materials
Data sharing is not applicable to this article, since no datasets were generated or analyzed during the current study.
Abbreviations
- B. trematum :
-
Bordetella trematum
- 16S-rtPCR:
-
16S ribosomal RNA sequencing
- MALDI-TOF MS:
-
Matrix-assisted laser desorption ionization time-of-flight mass spectrometry
- CDT:
-
Cytolethal distending toxin
- EUCAST:
-
European Committee on Antimicrobial Susceptibility Testing
- Piperacillin–tazobactam:
-
Tazocillin
- MIC:
-
Minimal inhibitory concentration
References
Vandamme P, Heyndrickx M, Vancanneyt M, Hoste B, De Vos P, Falsen E, et al. Bordetella trematum sp. nov., isolated from wounds and ear infections in humans, and reassessment of Alcaligenes denitrificans Rüger and Tan 1983. Int J Syst Bacteriol. 1996;46(4):849–58.
Novikov A, Marr N, Caroff M. A comparative study of the complete lipopolysaccharide structures and biosynthesis loci of Bordetella avium, B. hinzii, and B. trematum. Biochimie. 2018;159:81–92.
Dorittke C, Vandamme P, Hinz KH, Schemken-Birk EM, Wirsing von König CH. Isolation of a Bordetella avium-like organism from a human specimen. Eur J Clin Microbiol Infect Dis. 1995;14(5):451–4.
Hernández-Porto M, Cuervo M, Miguel-Gómez MA, Delgado T, Lecuona M. Diabetic leg ulcer colonized by Bordetella trematum. Rev Esp Quimioter. 2013;26(1):72–3.
Hamidou Soumana I, Linz B, Harvill ET. Environmental origin of the genus Bordetella. Front Microbiol. 2017. https://doi.org/10.3389/fmicb.2017.00028.
Chang D-H, Jin T-E, Rhee M-S, Jeong H, Kim S, Kim B-C. Draft genome sequence of Bordetella trematum strain HR18. Genome Announc. 2015. https://doi.org/10.1128/genomeA.01357-14.
Daxboeck F, Goerzer E, Apfalter P, Nehr M, Krause R. Isolation of Bordetella trematum from a diabetic leg ulcer. Diabet Med. 2004;21(11):1247–8.
Halim I, Ihbibane F, Belabbes H, Zerouali K, Mdaghri NE. Isolation of Bordetella trematum from bacteremia. Ann Biol Clin. 2014;72(5):612–4.
Almagro-Molto M, Eder W, Schubert S. Bordetella trematum in chronic ulcers: report on two cases and review of the literature. Infection. 2015;43(4):489–94.
Tena D, Medina MJ, Sáez-Nieto JA. Isolation of Xanthobacter species and Bordetella trematum in a patient with polymicrobial peritonitis. Infect Dis Clin Pract. 2017;25(5):e16–9.
Saksena R, Manchanda V, Mittal M. Bordetella trematum bacteremia in an infant: a cause to look for. Indian J Med Microbiol. 2015;33(2):305–7.
y Castro TR, Martins RCR, Dal Forno NLF, Santana L, Rossi F, Schwarzbold AV, et al. Bordetella trematum infection: case report and review of previous cases. BMC Infect Dis. 2019;19(1):485.
Majewski LL, Nogi M, Bankowski MJ, Chung HH. Bordetella trematum sepsis with shock in a diabetic patient with rapidly developing soft tissue infection. Diagn Microbiol Infect Dis. 2016;86(1):112–4.
Desurmont-Dupas MC, Cattoën C, Bonnet I. Bactériémie à Bordetella trematum dans un contexte d’immunosuppression [Bordetella trematum bacteremia in an immunosuppressed patient]. Med Mal Infect. 2018;48(8):547-9. https://doi.org/10.1016/j.medmal.2018.03.008.
Acknowledgements
We are grateful to the Bacteriology department of Tours University Hospital for the isolation and initial identification of Bordetella trematum. We thank ASV for Fig. 2a–c.
Funding
This work did not receive any specific funding from agencies or organizations in the public, commercial, or not-for-profit sectors.
Author information
Authors and Affiliations
Contributions
ML and KI conceived and designed the case; MM, KI, SG, ASV, LB, and BF followed up with and included the patient; ML and KI collected the data; ML, KI, BF, and AL wrote the first draft of the manuscript. All authors have carefully reviewed the manuscript and proposed significant modifications. All authors have approved the revisions and the submitted version. We confirm that there are no other persons who satisfied the criteria for authorship but are not listed. We further confirm that the order of authors listed in the manuscript has been approved by all of us. All authors read and approved the final manuscript.
Corresponding author
Ethics declarations
Ethical approval and consent to participate
We obtained ethical approval.
Consent to participate
Written informed consent was obtained from the patient for publication of this case report and any accompanying images. A copy of the written consent is available for review by the Editor-in-Chief of this journal.
Competing interests
ML, KI, AL, MM, SG, ASV, LB, and BF declare no conflicts of interest.
Additional information
Publisher’s Note
Springer Nature remains neutral with regard to jurisdictional claims in published maps and institutional affiliations.
Supplementary Information
Additional file 1.
Annex: result of 16S ribosomal RNA sequencing.
Rights and permissions
Open Access This article is licensed under a Creative Commons Attribution 4.0 International License, which permits use, sharing, adaptation, distribution and reproduction in any medium or format, as long as you give appropriate credit to the original author(s) and the source, provide a link to the Creative Commons licence, and indicate if changes were made. The images or other third party material in this article are included in the article's Creative Commons licence, unless indicated otherwise in a credit line to the material. If material is not included in the article's Creative Commons licence and your intended use is not permitted by statutory regulation or exceeds the permitted use, you will need to obtain permission directly from the copyright holder. To view a copy of this licence, visit http://creativecommons.org/licenses/by/4.0/. The Creative Commons Public Domain Dedication waiver (http://creativecommons.org/publicdomain/zero/1.0/) applies to the data made available in this article, unless otherwise stated in a credit line to the data.
About this article
Cite this article
Lacasse, M., Inyambo, K., Lemaignen, A. et al. Erysipelas of the right arm due to Bordetella trematum: a case report. J Med Case Reports 15, 365 (2021). https://doi.org/10.1186/s13256-021-02896-1
Received:
Accepted:
Published:
DOI: https://doi.org/10.1186/s13256-021-02896-1